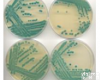
<em>缺陷</em><em>短波</em><em>单胞菌</em>,FJ-7

产品信息
ATCC可以提供以下类别生物标准品:细胞株(3000多种);菌株(15000多种);动植物病毒株(2500多种)以及重组物质等。现已成为可信赖的活体微生物、细胞系等获得、保存和发放的国家资源ZX,可用于水质检测,化妆品检测,食品与药品检测,为大中型科研提供严格质量体系控制的ATCC,CMCC,CICC,DSMZ标准菌株。ATCC菌种,ATCC标准菌株,质控菌株,可用于水质检测,化妆品检测,食品与药品检测,为大中型科研提供严格质量体系控制的ATCC,CMCC,CICC,DSMZ标准菌株。目前,ATCC有29,000多种不同品系可靠的动物细胞和微生物培养体,它能满足各科学团体对可信赖品系的需要。仅1981年就有39,000多培养物发放给全世界的科学工作者,并成功地用冷冻和冷冻干燥的方法保存各种细胞品系。 ATCC是一个非 (学会单位)无利润的公司,由各科学组织推选成员组成理事会进行管理。现有工作人员125人。参加的科学团体有:美国免疫协会、美国生物化学会、美国细胞生物学会、美国微生物学会、美国动物学会、美国遗传学会、原生动物学会和组织培养协会等16个学术组织。更多详情点击www.bnbiotech.comATCC菌种,ATCC标准菌株,质控菌株白色假丝酵母/白色念球菌ATCC 10231鲜绿青霉ATCC 10515桔青霉ATCC 1109蜡样芽孢杆菌ATCC 11778福氏志贺氏菌(Shigella flexneri)ATCC 12022表皮葡萄球菌ATCC 12228败毒梭菌Clostridium septicumATCC 12464阴沟肠杆菌ATCC 13047产气荚膜梭菌ATCC 13124荧光假单胞菌ATCC 13525婴儿双歧杆菌ATCC 15697短双歧杆菌ATCC 15700青春双歧杆菌ATCC 15703黑曲霉ATCC 16404恶臭假单胞菌ATCC 17485单增李斯特氏菌ATCC 19111溶组织梭菌Clostridium histolyticum ATCC 19401生孢梭菌ATCC 19404破伤风杆菌/梭菌Clostridium tetani ATCC 19406化脓性链球菌ATCC 19615黄杆菌属ATCC 21047近平滑念珠菌ATCC 22019变异链球菌ATCC 25175脆弱拟杆菌ATCC 25285洋葱假单胞菌ATCC 25416大肠埃希氏菌ATCC 25922金黄色葡萄球菌ATCC 25923宋内氏志贺氏菌(Sh.sonnei)ATCC 25931金黄色葡萄球菌ATCC 27217创伤弧菌ATCC 27562铜绿假单胞杆菌(绿脓杆菌)ATCC 27853粪肠球菌ATCC 29212金黄色葡萄球菌ATCC 29213两歧双歧杆菌ATCC 29521多形拟杆菌ATCC 29741粪肠球菌ATCC 33186空肠弯曲菌ATCC 33291金黄色葡萄球菌ATCC 33591大肠埃希氏菌ATCC 35218屎肠球菌ATCC 35667变异链球菌ATCC 35668迟缓真杆菌/迟缓埃格特菌ATCC 43055金黄色葡萄球菌ATCC 43300弗氏柠檬酸杆菌ATCC 43864淋病柰瑟氏菌ATCC 49226流感嗜血杆菌ATCC 49247肺炎链球菌ATCC 49619流感嗜血杆菌ATCC 49766粪肠球菌(高耐)ATCC 51299阪崎肠杆菌 ATCC 51329克柔念珠菌ATCC 6258金黄色葡萄球菌ATCC 6538枯草芽孢杆菌ATCC 6633肺炎克雷伯菌ATCC 700603热带念珠菌ATCC 750嗜热脂肪地芽孢杆菌ATCC 7953植物乳杆菌ATCC 8014大肠埃希氏菌ATCC 8739白色假丝酵母/白色念球菌ATCC 90029铜绿假单胞杆菌(绿脓杆菌)ATCC 9027枯草芽孢杆菌黑色变种ATCC 9372艰难梭菌Clostridium difficile ATCC 9689啤酒酵母ATCC 9763黑曲霉 ATCC 10582砖红链霉菌 ATCC19776白色葡萄球菌 ATCC8799皱褶青霉ATCC 10128黑曲霉ATCC 10864酿酒酵母ATCC 26603酿酒酵母ATCC 26785运动发酵单孢菌ATCC 29191假单胞杆菌ATCC 31554粪产碱杆菌ATCC 31555菅囊酵母ATCC 32691弗氏柠檬酸杆菌ATCC10787荚膜红细菌ATCC11166发根土壤杆菌(发根植物单胞菌)ATCC11325生孢梭菌(产芽孢梭状芽孢杆菌)ATCC11437痤疮丙酸杆菌ATCC11827地衣芽孢杆菌ATCC11946谷氨酸棒杆菌ATCC13032熏衣草灰链霉菌ATCC13306猪霍乱沙门氏菌猪霍乱亚种ATCC13312脱氮假单胞菌ATCC13867耐放射异常球菌ATCC13939绿针假单胞菌ATCC13985肠炎沙门氏菌肠炎亚种ATCC14028巨大芽孢杆菌ATCC14581吸水链霉菌奥萨霉素亚种ATCC15420长双歧杆菌ATCC15707放射性根瘤菌ATCC15955短密青霉ATCC16024副溶血性弧菌ATCC17802单核增生李斯特菌ATCC19115缺陷短波单胞菌ATCC19146师岗链霉菌ATCC19166脱氮付球菌ATCC19367丝状链霉菌ATCC19753裂殖壶菌ATCC20888产朊假丝酵母ATCC22023乙酸钙不动杆菌ATCC23055珊瑚链霉菌ATCC23901菲律宾链霉菌ATCC23905里氏木霉ATCC24449变异链球菌ATCC25175沙链霉菌ATCC25488酪丁酸梭菌ATCC25755蛎灰链霉菌ATCC27455黄曲霉ATCC28539噬糖盐红菌ATCC29252隐甲藻ATCC30772干酪乳杆菌干酪亚种ATCC334休哈塔假丝酵母ATCC34887停乳链球菌ATCC35666昆明链霉菌ATCC35682扣囊内孢霉ATCC36213马克斯克鲁维酵母ATCC36534串珠镰孢ATCC38946米曲霉ATCC42149树状微杆菌ATCC4358潮湿纤维单胞菌ATCC491荧光假单胞菌ATCC49642水螺菌ATCC49643产气肠杆菌ATCC49701串珠镰孢ATCC52539金黄色葡萄球菌ATCC6538P痤疮丙酸杆菌ATCC6919鼠李糖乳杆菌ATCC7469食油假单胞菌ATCC8062粘质沙雷氏菌ATCC8100蛾微杆菌ATCC8365粪产碱菌ATCC8750枯草芽孢杆菌ATCC9327空肠弯曲杆菌 ATCC 33291产气肠杆菌 ATCC13048金黄色葡萄球菌 ATCC 27217阴沟肠杆菌 ATCC 13047表皮葡萄球菌 CMCC(B) 29069阪崎肠杆菌 ATCC 29544弗氏柠檬酸杆菌 ATCC 43864肺炎克雷伯氏菌 ATCC 10031小肠结肠炎耶尔森氏菌 ATCC 23715亚利桑那沙门氏菌 CMCC(B) 47001热带念珠菌 ATCC 13803克柔假丝酵母菌 ATCC 14243光滑念珠菌 ATCC 15126创伤弧菌 ATCC 27562婴儿双歧杆菌 ATCC 15697德式乳杆菌保加利亚亚种 CICC6032生孢梭菌 CMCC(B)64941嗜热链球菌 CICC 6038Sphingobacterium compostiDSM18850猪霍乱沙门氏菌猪霍乱亚种DSM4224沼泽红假单胞菌DSM5859嗜盐细菌属DSMZ16465土壤伯克氏菌DSMZ18235烟酸芽孢杆菌DSMZ2923菲律宾链霉菌DSMZ40112=ATCC23905抗辐射链霉菌DSMZ41901短乳杆菌DSMZ6235乳酸片球菌JCM8791=DSM20284=NCIMB12174桃色欧文氏菌NBRC102418白色噬琼胶菌NBRC102603浮游球衣菌NBRC13543丁香假单胞菌NBRC14078睾丸酮丛毛单胞菌NBRC14951耐放射异常球菌NBRC15346烟酸芽孢杆菌NBRC15566新鞘氨醇单胞菌NBRC16725假交替单胞菌NCCB100134腐败希瓦氏菌NCIMB12202食油假单胞菌NCIMB6576普通变形杆菌NICPBP49027金龟子绿僵菌小孢变种NRRL13969大孢绿僵菌=金龟子绿僵菌大孢变种NRRL13970黄绿绿僵菌NRRL13971黄绿绿僵菌NRRL20422抗生链霉菌NRRL3238抗生链霉菌NRRL8044绿脓假单胞菌(绿脓杆菌) CMCC10104 金黄色葡萄球菌 CMCC 26003 枯草芽孢杆菌 CMCC 63501 大肠埃希氏菌(大肠杆菌) CMCC44102 乙型副伤寒沙门氏菌 CMCC 50094 短小芽孢杆菌 CMCC 63202 藤黄微球菌 CMCC 28001 费氏志贺氏菌 CMCC 51574 阴沟肠杆菌 CMCC 43501 产气肠杆菌 CMCC 45103 甲型副伤寒沙门氏菌 CMCC 50093 痢疾志贺氏菌 CMCC 51252 福氏志贺氏菌 CMCC 51572 宋氏志贺氏菌 CMCC 51592 鼠伤寒沙门氏菌 CMCC 50115 奇异变形杆菌 CMCC 49005 乙型溶血性链球菌 CMCC 32210 小肠结肠炎耶尔森氏菌 CMCC 52207 小肠结肠炎耶尔森氏菌 CMCC 52225 假结核耶尔森氏菌 CMCC 53504 变异链球菌 CMCC 32400 阪崎肠杆菌 CMCC 45401 单核增生李斯特菌 CMCC 54002 大肠杆菌 CMCC 44817 蜡状芽孢杆菌 CMCC 63302 嗜热脂肪芽孢杆菌 CMCC 63509 多粘类芽孢杆菌 CMCC 63512 白色假丝酵母 CMCC 98001 阪崎肠杆菌 CMCC 45401 单增李斯特菌 CMCC 54002 大肠埃希氏菌(大肠杆菌) CMCC44817 蜡状芽孢杆菌 CMCC 63302 多黏类芽孢杆菌 CMCC 63512 大肠埃希氏菌(大肠杆菌) CMCC44108 粪链球菌 CMCC(B) 32223 白色念珠菌 CMCC(F) 98001 金黄色葡萄球菌CMCC(B )26003 表皮葡萄球菌CMCC 26069 粪链球菌 CMCC(B) 32223 乙型溶血性链球菌CMCC(B) 32210 粪链球菌 CMCC(B) 32223 表皮葡萄球菌CMCC(B) 26069 普通变形杆菌CMCC(B) 49027 福氏志贺氏菌CMCC(B) 26003 痢疾志贺氏菌 CMCC(B) 51252 福氏志贺氏菌CMCC(B ) 51572 宋氏志贺氏菌CMCC(B) 51592 阴沟肠杆菌 CMCC(B) 45301 肠埃希氏菌 CMCC(B) 44103 单核增生性李斯特氏菌CMCC(B) 54002 已型副伤寒沙门氏菌CMCC(B) 50094 枯草芽孢杆菌CMCC(B) 63501 小肠结肠炎耶尔森氏菌CMCC(B) 52204 粘质沙雷伯氏菌CMCC(B) 41002 产气肠杆菌 CMCC(B) 45103 肺炎克雷伯氏菌CMCC(B) 46117 蜡样芽孢杆菌CMCC(B) 63301 短小芽孢杆菌CMCC(B) 63202 铜绿假单胞菌CMCC(B) 10104 大肠埃希氏菌CMCC(B) 44102 鼠伤寒沙门氏菌CMCC(B) 50115 黑曲霉 CMCC(B) 98003 大肠埃氏菌 8099非01 霍乱弧菌Vb0伤寒沙门氏菌CMCC(B) 50071 德氏乳杆菌保加利亚亚种 CICC 6045 乳链球菌 CICC 6016 瑞士乳杆菌 CICC 6024 巴氏醋杆菌巴氏亚种 CICC T006 丙酮丁醇梭菌(丙酮丁醇杆菌) CICC 8011 白球拟酵母 CICC 1040 粉状毕赤酵母 CICC 1688 斯氏油脂酵母 CICC 1715 贝酵母 CICC 1408 绿色木霉=木素木霉 CICC 13015 康宁木霉 CICC 13012 红曲霉 CICC 5036 平展米曲霉(米曲霉平展变种) CICC 2345 亮白曲霉 CICC 2360 泡盛曲霉 CICC 2253 泡盛曲霉 CICC 2252 泡盛曲霉 CICC 2254 米曲霉 CICC 2066 黑曲霉 CICC 2377 米曲霉 CICC 2080 米曲霉 CICC 2412 米曲霉 CICC 2014 莫格球拟酵母 CICC 1709 鲁氏接合酵母 CICC 1379 米曲霉 CICC 2412 米曲霉 CICC 2014 弗氏柠檬酸杆菌 CICC 20211 谢氏丙酸杆菌 CICC 10019 许旺酵母变种 CCRC 20332 大肠杆菌 CCRC 11447 DSMZ 18235巨大芽孢杆菌 ACCC 11107球型芽孢杆菌 ACCC 11096枯草芽孢杆菌 ACCC 10627黄色短杆菌 ACCC 11063产黄纤维单胞菌 ACCC 11055保加利亚乳杆菌 ACCC 10638干酷乳杆菌 ACCC 10639植物乳杆菌 ACCC 11095变形杆菌 ACCC 11002 恶臭假单胞菌 ACCC 10085 藤黄八叠球菌 ACCC 11001 乳酸链球菌 ACCC 10653乳酸链球菌 ACCC 11092乳酸链球菌 ACCC 11093乳酸链球菌 ACCC 11094蜡状芽孢杆菌 ACCC 11077荧光威克酵母 ACCC 20058 间型酒香酵母 ACCC 20233葡萄芽假丝酵母 ACCC 20201近平滑假丝酵母 ACCC 20221热带假丝酵母 ACCC 20005产朊假丝酵母 ACCC 20060汉逊德巴利酵母 ACCC 20010健强地霉 ACCC 20017阿拉伯糖醇汉逊酵母 ACCC 20205杰丁汉逊酵母 ACCC 20019土星汉逊酵母 ACCC 20020粉状毕赤酵母 ACCC 20026粘红酵母 ACCC 20030深红酵母 ACCC 20252灭酵母 ACCC 20200卡尔斯伯酵母 ACCC 20166 糖化酵母 ACCC 20204清酒酵母 ACCC 20045 许旺酵母 ACCC 20194泡盛曲霉 ACCC 30368臭曲霉 ACCC 30126烟曲霉 ACCC 30367黑曲霉 ACCC 30005 米曲霉 ACCC 303163海枣曲霉 ACCC 30164塔宾曲霉 ACCC 30165宇佐美曲霉 ACCC 30339金龟子绿僵菌 ACCC 30104 白僵菌 ACCC 30006 葡萄孢 ACCC 30384 头孢霉 ACCC 30146 金龟子绿僵菌小孢变种 ACCC 30194、NRRL 13969 绿色木霉=木素木霉 ACCC 30169、IFFI 3035 黄绿绿僵菌 ACCC 30196、NRRL 13971 黄绿绿僵菌 ACCC 30199、NRRL 20422 大孢绿僵菌=金龟子绿僵菌大孢变种 ACCC 30195、NRRL 13970 金龟子绿僵菌 ACCC 30131 平沙绿僵菌 ACCC 30105 红曲霉 ACCC 30342紫红曲霉 ACCC 30352 中华根霉 ACCC 30301厚孢根霉 ACCC 30302哈茨木霉 ACCC 30371 大丽花轮枝孢 ACCC 30308 白浅灰链霉菌 ACCC 40001抗生链霉菌 ACCC 40070天蓝色链霉菌 ACCC 40009淡天蓝色链霉菌 ACCC 40010 黄直丝链霉菌 ACCC 40046弗氏链霉菌 ACCC 40012刺孢吸水链霉菌 ACCC 40018 紫色直丝链霉菌 ACCC 40032刺孢吸水链霉菌昆明变种 ACCC 40020 吸水链霉菌紫色变种 ACCC 40034淡紫灰链霉菌 ACCC 40024孔雀石绿链霉菌 ACCC 40026玫瑰褐链霉菌 ACCC 40123珊瑚色诺卡氏菌 ACCC 40100鸡腿蘑(毛头鬼伞) ACCC 50400 鸡油菌 ACCC 50878 宽圆羊肚菌 ACCC 50759 长根菇(长根奥德磨) ACCC 50053 异型酒香酵母 ACCC 20234 嗜酸乳杆菌 ACCC 11073巨大芽孢杆菌 ACCC 11011 褐球固氮菌 ACCC 10096 枯草芽孢杆菌 ACCC 10157 红平红球菌 ACCC 10543 谷氨酸棒杆菌 ACCC 16522蜡蚧轮枝孢菌 ACCC 32146 泾阳链霉菌 ACCC 40126 诺尔斯氏链霉菌 ACCC 40029 吸水链霉菌应城变种 ACCC 40053 刺孢吸水链霉菌北京变种 ACCC 40074 浅灰链霉菌杭州变种 ACCC 40075 ATCC菌种,ATCC标准菌株,质控菌株

![9ml <em>缺陷</em>假<em>单胞菌</em>[ATCC19146][<em>缺陷</em><em>短波</em><em>单胞菌</em>][<em>缺陷</em>性假<em>单胞菌</em>](https://item.yiqi.com/pic/CovPic/4/3267272467114877229-14.png)







